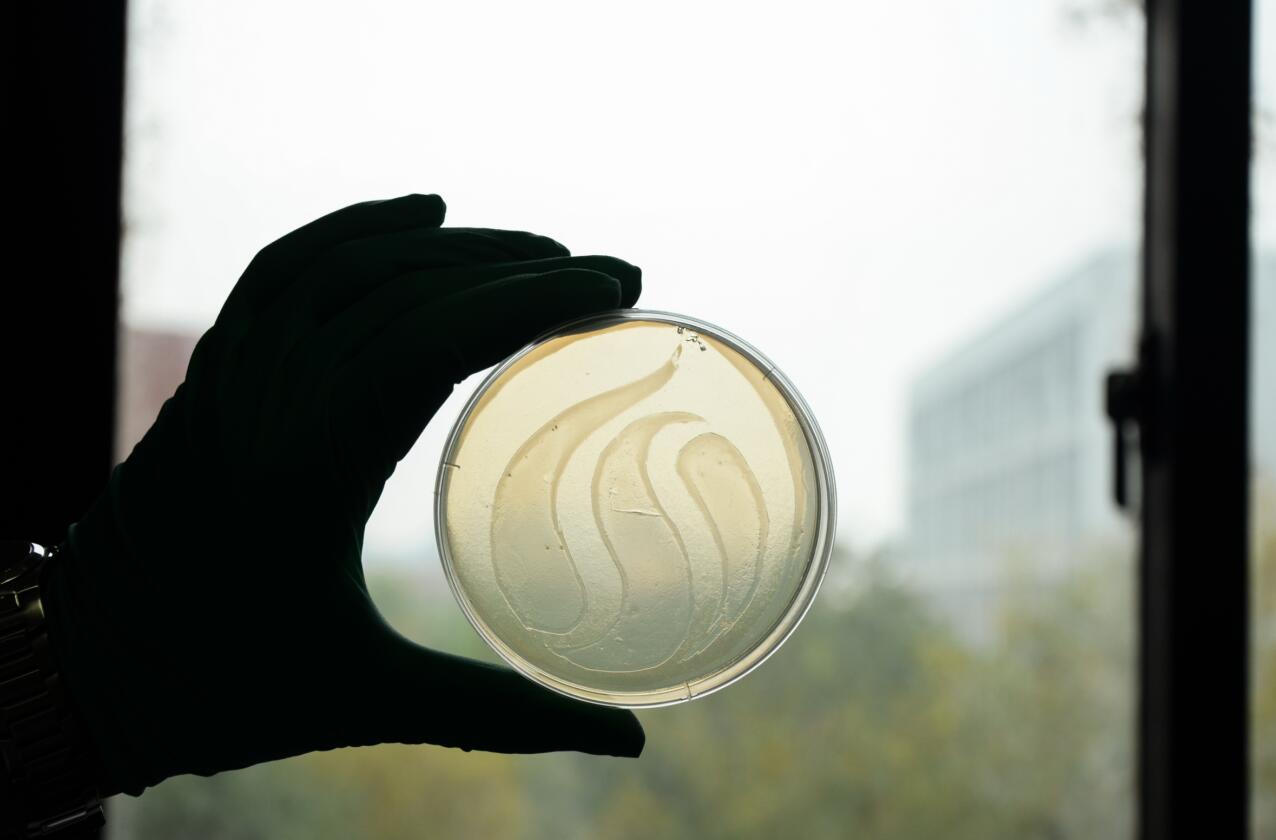

11月29日,“最美科研人”浙江大生命科学研究院第二届摄影大赛颁奖典礼在纳米楼457报告厅顺利举行,至此,历时一个多月的摄影大赛圆满落下帷幕。
本次大赛面向我院全体师生员工,旨在鼓励全院师生在科研活动中发掘最美瞬间,展现浙大生研院的科研风尚,创造出学术性与艺术性交融的精美作品,加强科研人员之间的交流合作。自11月中旬大赛开展以来,共收到来自24位参赛选手的作品36件。大赛评委会由浙江大学宣传部卢绍庆老师、汪晓勇老师、周立超老师组成。评委们从主题、内容、技巧等方面对参赛作品进行了综合评价,最终评选出10个等级奖、1个“最佳创意奖”以及1个“最高人气奖”作品。
获奖作品赏析:

一等奖 《见微知著》 作者:陈亲富 易琦

二等奖 《研值》 作者:赵红霞 周航

二等奖 《烦恼会解决烦恼》 作者:李静

二等奖 《Alice in The Wonderland》 作者:羌姝

二等奖 《微微一笑很Science》 作者:戎妍

三等奖《黑暗中探索未知》 作者:吴超

三等奖 《致青春》 作者:张娜

三等奖 《最可爱的人》 作者:赵龙雯

三等奖 《专注的眼睛》 作者:石景成

三等奖 《Reflection》 作者:朱鑫海
最佳创意奖 《LSIer的院校情怀》 作者:张心愿

最高人气奖 《一位海归辣妈的科研生活》 作者:刘静波




